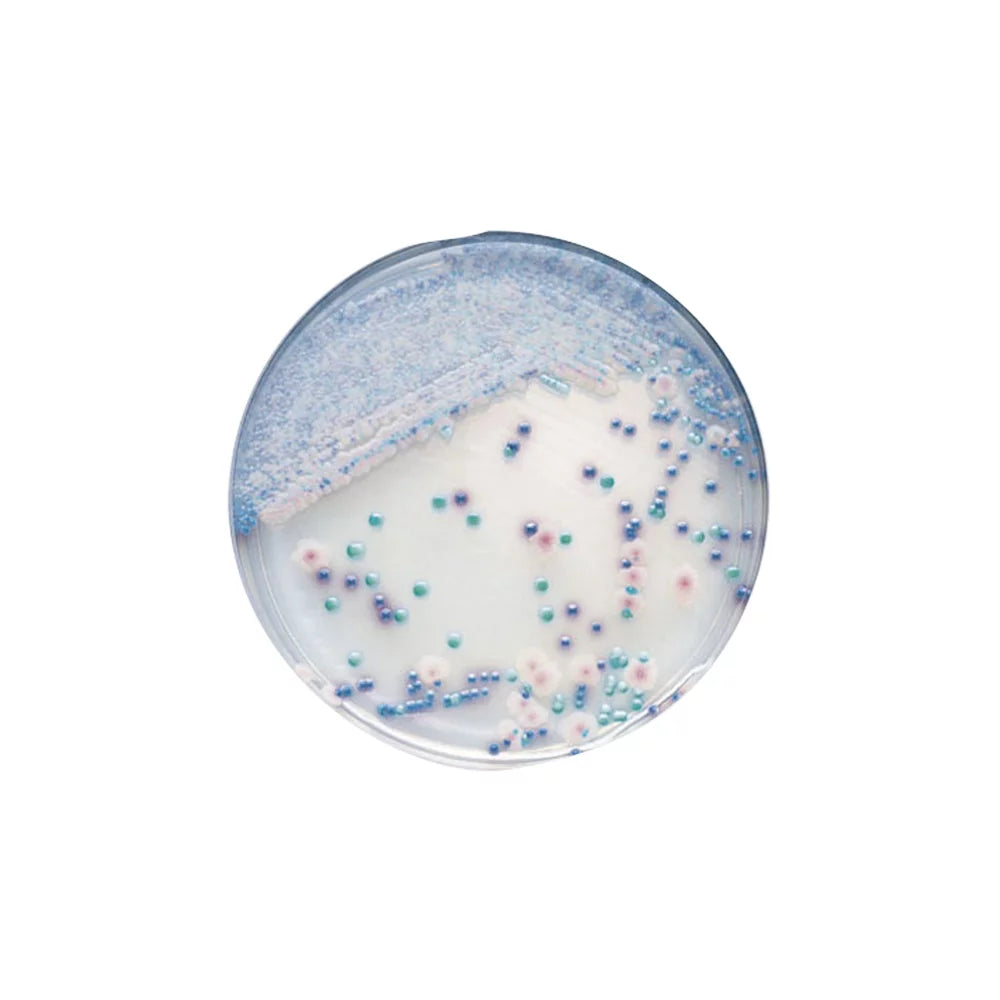

BD CHROMagar™ Candida Medium
Konnte die Verfügbarkeit der Abholung nicht laden.
Produkte, die nicht im Portal aufgeführt sind, aber benötigt werden, können über „Produktanfrage “ angefragt werden. Diese Anfragen werden künftig direkt an Ihren zuständigen Praxismanager weitergeleitet, der über die Freigabe entscheidet.
BD CHROMagar™ Candida Medium – ein hochwertiges Selektivmedium zur schnellen und präzisen Differenzierung von Candida-Arten in mikrobiologischen Labors. Es ist ideal für die Identifikation und Diagnostik und bietet eine einfache Anwendung mit klaren Ergebnissen.
Produkteigenschaften:
- Anwendung: Selektivmedium zur Identifikation und Differenzierung von Candida-Arten
- Lagerung: Nach Erhalt bis unmittelbar vor Gebrauch im Dunkeln bei 2–8 °C aufbewahren
- Spezielle Anforderungen: Lichtgeschützte Lagerung zur Stabilität und Wirksamkeit des Mediums
BD CHROMagar™ Candida Medium bietet eine verlässliche Lösung für die Candida-Diagnostik und sorgt für reproduzierbare, schnelle und präzise Ergebnisse in der mikrobiologischen Untersuchung.